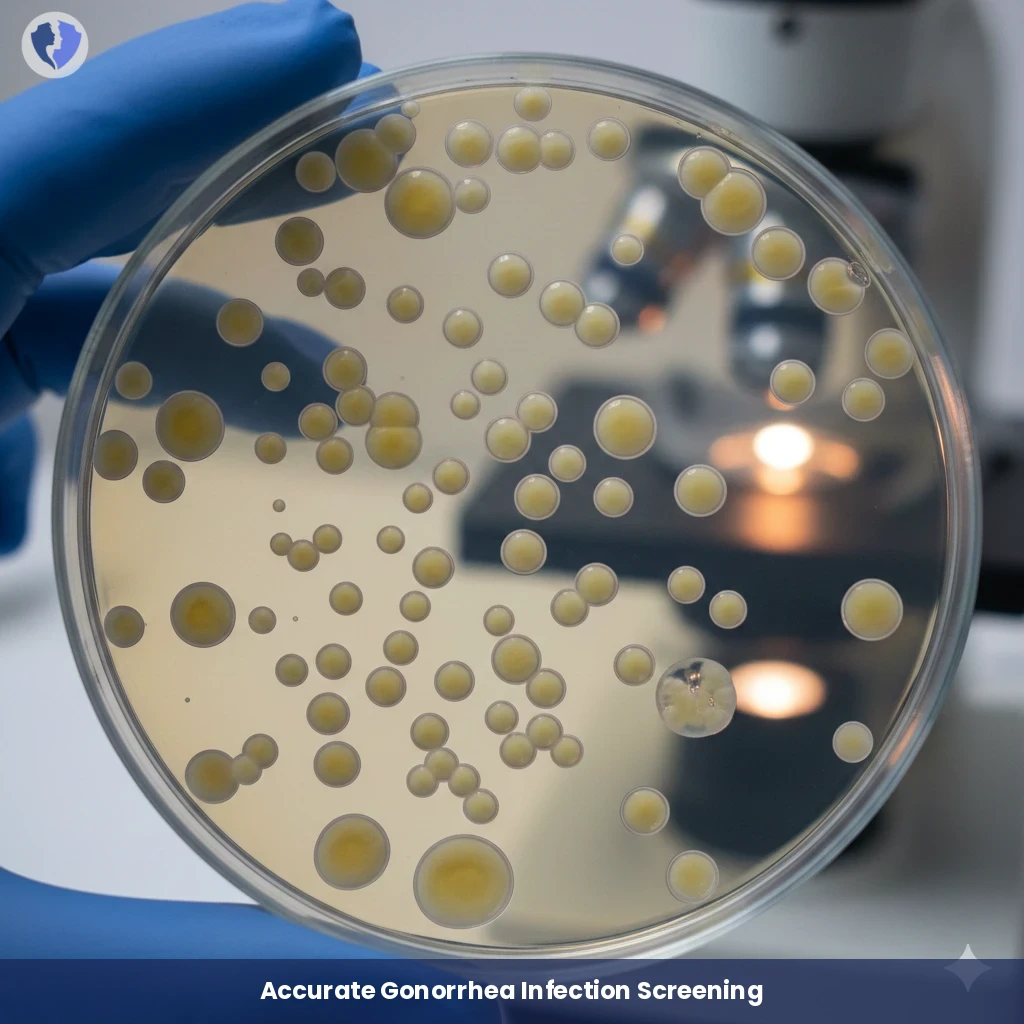
Gonorrhea Bacterial Culture - Neisseria Gonorrhoeae Culture

Service Details
Gonorrhea Bacterial Culture - Neisseria Gonorrhoeae Culture
Microbiological examination is considered the gold standard for diagnosing Neisseria gonorrhoeae infection, the bacterium that causes gonorrhea. The sample (from the cervix, urethra, rectum, or oropharynx) is inoculated onto selective, enriched culture media (such as Thayer-Martin medium). After incubation, suspected bacterial colonies are identified by their morphological, biochemical, and microscopic characteristics, with antibiotic susceptibility testing (antibiogram) performed on positive isolates.